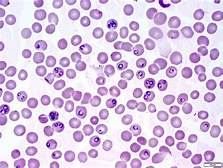

Diversity of Life: Domain Eukarya, Kingdom Protista
Diversity of Life: Domain Eukarya, Kingdom Protista
Protists are the "miscellaneous" Kingdom of life. They are all organisms similar in many ways to plants, fungi, or animals; yet they don't quite fit into these classifications. As a result, they are traditionally divided into three groups: animal-like Protists (also called Protozoa), plant-like Protists (also called algae), and fungus-like Protists. You will note in the text that advances in DNA and biochemical technology are changing this grouping. They have three characteristics in common:
- Eukaryotic.
- Unicellular or, if multicellular, the cells are not organized into specific tissues showing division of labor.
- Have both sexual and asexual modes of reproduction.
The animal-like group has traditionally been divided into groups based on their means of motion: amoeboid motion (the sarcodines), flagellae (flagellates), or cilia (ciliates). A fourth group are primarily parasitic (apicocomplexa).
The plant-like group includes a wide range of organisms, both unicellular and multicellular) that all do photosynthesis—the key factor.
The fungus-like group includes organisms that primarily feed on decaying matter.
As you will see from your text or web sites, the kingdom has been reorganized today based on molecular data. When you expire the other eukaryotic kingdoms you will see that they are multicellular and start from a single common ancestral group. That is not the case for the protists; they appear to have multiple origins.
Good road map through this Kingdom. You may find that this site is good reference for you as you navigate this diverse Kingdom!
There are many species in each group. Examples are characteristic of the group and are of medical significance.
a. Parabasalids have a row of bundled microtubules extending the length of the cell. Examples: Tichomonas vaginalis, Trichonympha campanula.
 Trichomonas vaginalis
Trichomonas vaginalis
b. Diplomonads have three flagellae at the anterior end and one at the trailing end. Example: Giardia lamblia.
 Giardia lamblia
Giardia lamblia
Examples are characteristic of the group.
a. Euglenoids are free-living flagellated cells with a flagellum at the anterior end. Two-thirds of the species are photosynthetic; the other one-third retain the ancestral form and feed on other cells. They have a cytoskeleton called a pellicle. Examples: Euglena spp.
 Euglena
Euglena
b. Kinetoplastids are mostly trypanosomes and almost all are parasites. Some are causative agents of serious human diseases such as african sleeping sickness, Chagas disease, and leishmaniasis. Examples: Trypanosoma brucei, Trypanosoma cruzi, Leishmania donovani.

 Leismanis donovani
Leismanis donovani
a. Foraminiforans consist of a shell like skeleton with one or more chambers. They form multiple pseudopods that ingest microorganism they contact. Their shells accumulate and have been used in climate studies when extracted from sediment. Keep in mind that these intricate shell structures are formed by a single celled animal.
 Foraminfera
Foraminfera
 Foraminiferan Shells
Foraminiferan Shells
b. Radiolarians have shells made of silicon rods that interconnect. The cell has many vacuoles in the outer layer. Again, these elaborate shell like structures are produced by a single celled animal. There would by cytoplasm flowing out along the spikes to capture food particles and then carrying them back down to the main part of the cell.
 Radiolarian
Radiolarian

Ciliates have cilia over all or part of the cell and one or more membrane sacs (alveoli) under the cell surface. The cilia move either the cell or the water surrounding the cell. The cell has a pellicle and some have trichocysts—a thread-like structure that is barbed on the end. Ciliates may also have two types of nuclei—a macronucleus that is involved in vegetative activities of the cell and a micronucleus used in sexual transfer of genetic material. Examples: Paramecium spp, Didinium.
a. Dinoflagellates have cellulose in the alveoli which often gives the appearance of armor plating. Many are photosynthetic and many are parasites. They are the organisms that cause “red” tides—accumulations of uncounted billions of cells that actually turn the water red. These organisms produce a toxin which can be passed to humans through shellfish that feed on the dinoflagellates. Examples: Gonyaulax spp, Gymnodinium spp, Peridinium spp.
 Red Tide in York River
Red Tide in York River
 Florida Gulf Coast
Florida Gulf Coast
 Peridinium
Peridinium
b. Apicocomplexans are all parasites. The best known are the Plasmodium species that cause malaria. They are transmitted by mosquito vectors.

After watching this video, think about the impacts on the entire ecosystem if this were successful. Birds, dragonflies, bats, spiders all prey on mosquitos. What would elimination do to the food web? Clearly there are ethical issues that need to be considered before attempting to drive an entire species extinct.
a. Many are photosynthetic. These include the yellow-green algae and golden algae. Yellow-green algae produce chlorophyll c which gives them their characteristic color. Golden algae produce silica scales. Coccolithophores form calcium carbonate plates that contribute to limestone formations. A large number of these organisms are the diatoms. They have a large number of shapes but all are formed from silica shells that have two halves that fit like a box. The last group are the brown algae. These are tough, filamentous organisms that are frequently found along rocky shores in the tidal zone. Being tough, they can withstand the action of the surf. Kelp is the largest of the brown algae and are a major factor in their ecosystem. Extracts from kelp are used as ingredients in ice cream, pudding, jellies, salad dressings, toothpaste, cosmetics, floor polish.
 Golden Algae
Golden Algae

 Diatoms--silica shells
Diatoms--silica shells
 Fucus--a brown algae
Fucus--a brown algae
Protist Image Gallery from University of Montreal
b. Colorless stamenopiles consist of the oomycotes, the water molds. They are decomposers in water environments and opportunistic parasites. They were classified with fungi at one time but have flagellated egg cells--no fungi has that. Examples: Phytophtora spp, Plasmopara viticola.
Potato Blight. Phytopthera infestans is the organism that caused the potato famine in Ireland in the 1840's. If you have Irish ancestors, that may have been the reason they immigrated to America. They also infect tomatoes.

Sudden Oak Death. Another water mold that causes death of oak trees. It is so far confined California where it was apparently introduced from Asia. Here is a link describing the disease.
 Sudden Oak Death results
Sudden Oak Death results
 Downy Mildew on grapes - Plasmopara viticola
Downy Mildew on grapes - Plasmopara viticola
Red algae are found in warm waters and usually deeper, calm waters. Red light does not penetrate into deeper waters. Therefore the red pigment used for photosynthesis does not lose energy by reflecting red light - that color never reaches the algae. They only appear red when illuminated with full spectrum light. They tend to be more fragile than other algae. Most have a branching pattern of growth. Agar and carrageenan are extracted from the cell walls of these algae. Agar is used as a culture medium, for capsules in drugs, and as a thickener for jellies. Carrageenan is also used as a thickening agent for sauces and dairy products. Example: Porphyra spp.

Green algae are the group most closely related to land plants. They have the same types of pigments and store excess energy as starch. They also have cellulose fibers in the cell walls. Most are fresh-water although some are marine organisms. They range from tiny single cells to long filaments to sheet-like structures. Examples: Volvox spp, Spirogyra spp, Chlamydomonas spp, Ulva spp.
a. Amoebas are cells that move via pseudopodia, flowing cytoplasm. Most do not have a cell wall or pellicle, although some may form a shell-like structure called a test. Most freshwater although some are specialized as internal parasites. Examples: Entomoeba histolytica, Amoeba proteus.
b. There are two types of slime molds. Cellular slime molds have actual amoeba cells that live individually before congregating and forming a multinucleate organism for reproduction. They are very common in the local Tidewater area. Example: Dictyostelium discoideum.
 Cellular Slime Mold - Common name is "dog vomit"
Cellular Slime Mold - Common name is "dog vomit"
Plasmodial slime molds never separate into individual amoeboid cells.They stay in the slug-like phase until ready to reproduce.